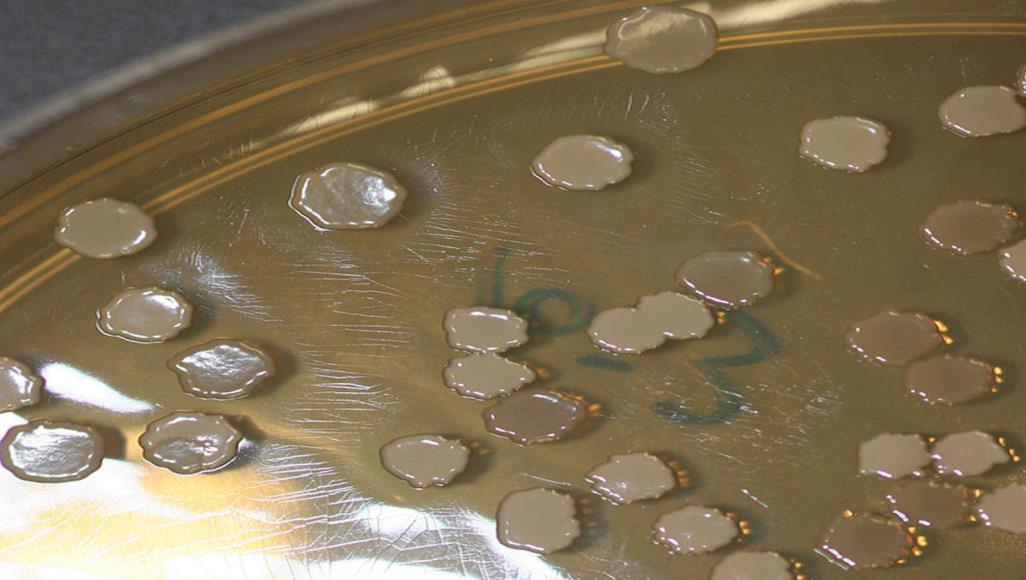
تشابه مدهش بين الذاكرة البكتيرية وعصبونات الدماغ البشري الباحثون استخدموا الضوء لطباعة "ذاكرة" على الغلاف الحيوي للبكتيريا "العصوية الرقيقة" (ويكيبيديا)

طارق قابيل
اكتشف علماء الأحياء أن الأغشية الحيوية البكتيرية تحتوي على “ذاكرة” تعمل بطريقة مشابهة لطريقة عمل الخلايا العصبية البشرية، مما يفتح المجال لاستخدام نتائج هذه الدراسة في تطوير علوم الحوسبة البيولوجية والبيولوجيا الاصطناعية.
ووجد البروفيسور غورول سويل وزملاؤه في جامعة كاليفورنيا بسان دييغو، أن خلايا البكتيريا المحفزة بالضوء تذكرت تعرضها للضوء بعد ساعات من التحفيز لأول مرة.
وتظهر النتائج المنشورة في دورية “أنظمة الخلايا” يوم 27 أبريل/نيسان الماضي، أوجه تشابه مدهشة بين الكائنات الأولية الأحادية الخلية والعصبونات المعقدة التي تعالج الذاكرة في الدماغ البشري.
البكتيريا تتذكر
الغشاء الحيوي البكتيري الرقيق (البيوفيلم) هو تكدس معقد للكائنات المجهرية الوحيدة الخلية، ويتسم بإفراز نسيج خارج الخلية، وخلاياه ملتصقة بشدة بعضها ببعض، وفي غالب الأحيان تلتصق هذه الخلايا بسطح صلب.
استخدم الفريق بكتيريا بسيطة تسمى “العصوية الرقيقة”، وهي نوع من “البكتيريا الإيجابية غرام” تتواجد في التربة، وعرضوها لومضة من ضوء الليزر الأزرق مدتها خمس ثوان.
وجد البحثون أن هذا الضوء يتسبب في تغير داخل الغشاء، حيث تتدفق الأيونات باستمرار من الخلية ثم تعود إليها مرة أخرى، وظل هذا التأثير مستمرا لعدة ساعات بعد التعرض للضوء.
وقال البروفيسور سويل -وهو عالم الأحياء الجزيئية بجامعة كاليفورنيا- لموقع “ساينس أليرت” العلمي إن “عملنا يُظهر لأول مرة أن البكتيريا البسيطة يمكنها ترميز الذاكرة على مستوى الغشاء الخلوي، وهو ما يشبه عملية ذاكرة الخلايا العصبية في الدماغ”.
وأضاف “لقد فوجئنا عندما وجدنا أن الآلية التي يتم من خلالها تكوين الذاكرة متشابهة بين البكتيريا والخلايا العصبية، لأن هذه أنظمة تطورية بعيدة جدا عن بعضها”.
جذور قديمة
بعد اكتشافات حديثة من مختبر سويل أكدت أن البكتيريا تستخدم القنوات الأيونية للتواصل مع بعضها البعض، اقترحت الدراسة الجديدة أن البكتيريا قد يكون لديها أيضا القدرة على تخزين المعلومات حول حالاتها الماضية.
وعلى الرغم من أنه يبدو كنوع من تكوين الذاكرة، فإنه بالتأكيد ليس هو نفس ما يحدث في أدمغتنا، فعندما “تطلق” الخلايا العصبية السيال العصبي في أدمغتنا، تتدفق الأيونات فتخبر العصبون التالي بأنه قد تلقى رسالة.
ينتج عن تدفق الأيونات فرق في الشحنة الكهربائية بين داخل الخلية وخارجها، ومن المعروف أن هذا التغيير في إمكانات الغشاء الخلوي للخلايا العصبية منخرط في عملية تكوين الذاكرة.
الأهمية الهائلة لهذا التغيير هي نقل المعلومات بين العصبونات أو نقل المعلومات بين أنسجة الجسم والدماغ. والآن، يبدو أن شيئا مشابها يمكن أن يحدث في الأغشية الحيوية للبكتيريا، ولكن لا نعرف حتى الآن سبب حدوثه، أو هل تستخدمه البكتيريا بالفعل في بيئاتها العادية.
ويشرح سويل قائلا “لا نعرف حتى الآن سبب امتلاك البكتيريا لهذه الخاصية.. من الواضح أننا بحاجة إلى دراسة أعمق لما يعنيه أن تتعرض البكتيريا للضوء فتكوّن ذكريات”.
وأضاف أنه “حتى قبل بضع سنوات لم يكن الناس يعتقدون أن الخلايا البكتيرية والخلايا العصبية تتشابه في أي شيء لأنها خلايا مختلفة.. وهذا الاكتشاف في البكتيريا يوفر أدلة وفرصة لفهم بعض السمات الرئيسية للدماغ في نظام أبسط”.
ذاكرة جماعية
ليست هذه هي المرة الأولى التي يعثر فيها الباحثون على بكتيريا “تتذكر” الأشياء. فقبل بضع سنوات، وجد فريق آخر من الباحثين أن البكتيريا لها ذاكرة جماعية زادت من تحملها للإجهاد عند تعرضها للملح.
ويأمل فريق سويل أن يتمكن من استخدام النتائج الحديثة التي توصل إليها لتطوير نظم الحوسبة البيولوجية والبيولوجيا الاصطناعية، ولكن على ما يبدو فإن ذلك قد يحتاج إلى المزيد من الوقت.